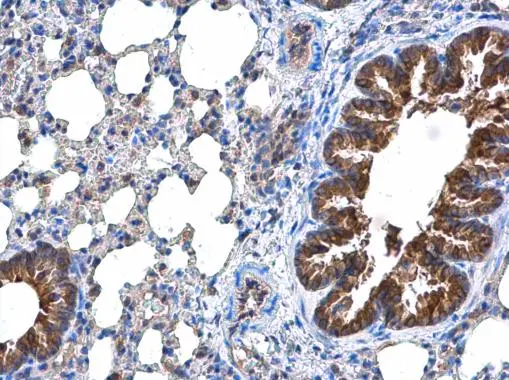
DOCK8 antibody detects DOCK8 protein at cytoplasm in mouse lung by immunohistochemical analysis. Sample: Paraffin-embedded mouse lung. DOCK8 antibody (GTX130251) diluted at 1:500. 
 Antigen Retrieval: Citrate buffer, pH 6.0, 15 min

DOCK8 antibody detects DOCK8 protein by western blot analysis. Various whole cell extracts (30 μg) were separated by 5% SDS-PAGE, and the membrane was blotted with DOCK8 antibody (GTX130251) diluted at a dilution of 1:1000.
DOCK8 antibody
GTX130251
ApplicationsWestern Blot, ImmunoHistoChemistry, ImmunoHistoChemistry Paraffin
Product group Antibodies
ReactivityHuman, Mouse
TargetDOCK8
Overview
- SupplierGeneTex
- Product NameDOCK8 antibody
- Delivery Days Customer9
- Application Supplier NoteWB: 1:500-1:3000. IHC-P: 1:100-1:1000. *Optimal dilutions/concentrations should be determined by the researcher.Not tested in other applications.
- ApplicationsWestern Blot, ImmunoHistoChemistry, ImmunoHistoChemistry Paraffin
- CertificationResearch Use Only
- ClonalityPolyclonal
- Concentration0.1 mg/ml
- ConjugateUnconjugated
- Gene ID81704
- Target nameDOCK8
- Target descriptiondedicator of cytokinesis 8
- Target synonymsHEL-205, HIES2, MRD2, ZIR8, dedicator of cytokinesis protein 8, 1200017A24Rik, epididymis luminal protein 205
- HostRabbit
- IsotypeIgG
- Protein IDQ8NF50
- Protein NameDedicator of cytokinesis protein 8
- Scientific DescriptionDOCK8 is a member of the DOCK180-related (DOCK1; MIM 601403) protein family (Ruusala and Aspenstrom, 2004 [PubMed 15304341]).[supplied by OMIM]
- ReactivityHuman, Mouse
- Storage Instruction-20°C or -80°C,2°C to 8°C
- UNSPSC12352203